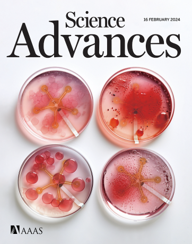

JOURNAL PUBLICATIONS

20. A. Bateman, G. Byun, S. Oh, R. Herbert, M. Perera, J. Lee, K. Kim, Y. Huang, B. Rigo, M. Guess, J. Newsome, Z. Bercu, V. Teodorescu, H. Li, J. Moon, WH. Yeo.
“Wireless, battery-free self-detecting smart arteriovenous graft for stenosis diagnosis in dialysis patients”
Biosensors and Bioelectronics, 2025. [LINK]

19. J. Lee, A. Bateman, MH. Kim, B. Rigo, H. Kim, J. Lee, YH. Choi, R. Herbert, DH. Lee, WH. Yeo.
“Non-surgical, in-stent membrane bioelectronics for long-term intracranial pressure monitoring”
Advanced Healthcare Materials, 14 (13), 2025. Selected as a journal cover. [LINK]
18. J. Lee, H. Kim, HR. Lim, YS. Kim, TT. Hoang, J. Choi, GJ. Jeong, H. Kim, R. Herbert, I. Soltis, KR. Kim, SH. Lee, Y. Kwon, Y. Lee, YC. Jang, WH. Yeo.
“Large-scale smart bioreactor with fully integrated wireless multivariate sensors and electronics for long-term in situ monitoring of stem cell culture”
Science Advances, 10 (7), 2024. Selected as a journal cover.[LINK]

17. R. Herbert, P. Mocny, Y. Zhao, T.C. Lin, J. Zhang, M. Vinciguerra, S. Surprenant, W.Y. Chan, S. Kumar, M.R. Bockstaller, K. Matyjaszewski, C. Majidi.
“Thermo-mechanically stable, liquid metal embedded soft materials for high-temperature applications”
Advanced Functional Materials, 2023. [LINK]


15. R. Herbert, M. Elsisy, B. Rigo, H. Lim, H. Kim, C. Choi, S. Kim, S. Ye, W. Wagner, Y. Chun, WH, Yeo.
“Fully implantable batteryless soft platforms with printed nanomaterial-based arterial stiffness sensors for wireless continuous monitoring of restenosis in real-time”
Nano Today, 46 (1), 2022. [LINK] [PDF] [Covered in Nano Today News]


13. N. Rodeheaver, H. Kim, R. Herbert, H. Seo, WH. Yeo.
“Breathable, wireless thin-film wearable biopatch using noise-reduction mechanisms”
ACS Applied Electronic Materials, 4 (503), 2022. [LINK]

12. N. Zavanelli, H. Kim, J. Kim, R. Herbert, M. Mahmood, Y. Kim, S. Kwon, N. Bolus, B. Torstrick, C. Lee, WH. Yeo.
"At-home wireless monitoring of acute hemodynamic disturbances to detect sleep apnea and sleep stages via a soft sternal patch"
Science Advances, 7 (52), 2021. [LINK]

11. N. Rodeheaver, R. Herbert, Y. Kim, M. Mahmood, H. Kim, J. Jeong, WH. Yeo.
“Strain-isolating materials and interfacial physics for soft wearable bioelectronics and wireless, motion artifact-controlled health monitoring”
Advanced Functional Materials, 31 (36), 2021. [LINK] [Covered in MedicalXpress]

10. R. Herbert, H. Lim, S. Park, J. Kim, WH. Yeo.
“Recent Advances in Printing Technologies of Nanomaterials for Implantable Wireless Systems in Health Monitoring and Diagnosis”
Advanced Healthcare Materials, 10 (17), 2021. [LINK]

9. Y. Kwon, Y. Kim, S. Kwon, M. Mahmood, H. Lim, S. Park, S. Kang, J. Choi, R. Herbert, Y. Jang, Y. Choa, WH. Yeo.
“All-printed nanomembrane wireless bioelectronics using a biocompatible solderable graphene for multimodal human-machine interfaces”
Nature Communications, 11 (1), 2020. [LINK]


7. S. Mishra, Y. Kim, J. Intarasirisawat, Y. Kwon, Y. Lee, M. Mahmood, H. Lim, R. Herbert, K. Yu, CS. Ang, WH. Yeo.
“Soft, wireless periocular wearable electronics for real-time detection of eye vergence in a virtual reality toward mobile eye therapies”
Science Advances, 6 (11), 2020. [LINK]

6. R. Herbert, J. Jeong, WH. Yeo.
“Soft material-enabled electronics for medicine, healthcare, and human-machine interfaces”
Materials, 13 (3), 2020. [LINK]

5. Y. Kim, A. Basir, R. Herbert, J. Kim, H. Yoo, WH. Yeo.
“Soft materials, stretchable mechanics, and optimized designs for body-wearable compliant antennas”
ACS Applied Materials and Interfaces, 12(2), 2020. [LINK]

4. M. Mahmood, D. Mzuikwao, Y. Kim, Y. Lee, S. Mishra, R. Herbert, A. Duarte, CS. Ang, WH. Yeo.
“Fully portable and wireless universal brain-machine interfaces enabled by flexible scalp electronics and deep learning algorithm”
Nature Machine Intelligence, 1 (9), 2019. [LINK] [Covered in Forbes, Medgadget, Tech Xplore, and more]

3. R. Herbert, S. Mishra, H. Lim, H. Yoo, WH. Yeo.
“Fully printed, wireless, stretchable implantable biosystem toward batteryless, real-time monitoring of cerebral aneurysm hemodynamics”
Advanced Science, 6 (18), 2019. Selected as a journal cover. [LINK] [PDF] [Covered in Medgadget, 3D Printing Industry, Tech Xplore, EE Times, and more]

2. Y. Kim, M. Mahmood, Y. Lee, NK. Kim, S. Kwon, R. Herbert, D. Kim, HC. Cho, WH. Yeo.
“All-in-one, wireless, stretchable hybrid electronics for smart, connected, and ambulatory physiological monitoring”
Advanced Science, 6 (17), 2019. Selected as a journal cover. [LINK] [Covered in Tech Explorist, Medgadget, and more]

1. R. Herbert, JH. Kim, Y. Kim, HM. Lee, WH. Yeo.
“Soft material-enabled, flexible hybrid electronics for medicine, healthcare, and human-machine interfaces”
Materials, 11 (187), 2018. [LINK]
CONFERENCE PROCEEDINGS
11. E. Grove, ON. Olaoye, M. Ruiz, C. Reid, G. Freedman, M. McClung, K. Stack, N. Jackson, R. Herbert.
“Printable, liquid metal embedded fluoroelastomers for space-grade soft electronics”
SPIE Soft Mechatronics and Wearable Systems, 2026.
10. J. Zuazola, A. Maharjan, T. Dixon, L. Hyder, L. Nguyen, M. Kazim, D. Goswami, R. Herbert.
“Soft robotics and sensor-embedded benchtop model to understand inferior vena cava filter complications”
SPIE Soft Mechatronics and Wearable Systems, 2026.
9. R. Herbert.
“Wireless vascular bioelectronic systems with printed soft sensors and flexible electronic stents”
SPIE Soft Mechatronics and Wearable Systems, 2026.
8. ON. Olaoye, M. Ruiz, C. Reid, G. Freedman, R. Herbert.
“Multifunctional, liquid metal embedded soft materials towards seals with embedded electronics for space applications”
SPIE Soft Mechatronics and Wearable Systems, 2025.
7. A. Maharjan, JM. Zuazola, A Bui, R. Herbert.
“Soft, sensor-embedded cererbal aneurysm benchtop model towards biomechanical studies of rupture risks”
SPIE Soft Mechatronics and Wearable Systems, 2025.
6. R. Herbert.
“Wireless vascular bioelectronic systems with printed soft sensors and flexible electronic stents”
SPIE Soft Mechatronics and Wearable Systems, 2024.
5. R. Herbert, A. Xu, P. Mocny, L. Li, H. Choset, K. Matyjaszewski, C. Majidi.
“Viton and Liquid Metal Composite Material Systems for In-Space Applications and Additive Manufacturing”
AIAA SCITECH, 2024.
4. B. Liu, R. Herbert, WH. Yeo, F. Hammond.
“Kirigami skin-based flexible whisker sensor”
IEEE/RSJ International Conference on Intelligent Robots and Systems, 2022.
3. M. Elsisy, R.Herbert, WH. Yeo, J. Pacella, Y. Chun.
“Development of a nanosensor-integrated stent for wireless, continuous monitoring of restenosis progression”
Nano-, Bio-, Info-Tech Sensors and 3D Systems III. Vol. 11590, 2021.
2.R. Herbert, WH. Yeo.
“Stretchable, implantable nanomembrane biosensor for wireless, real-time monitoring of hemodynamics”
IEEE ECTC, 2019.
1. Y. Kim, M. Mahmood, S. Kwon, R. Herbert, WH. Yeo.
“Robust human-machine interfaces enabled by a skin-like electromyogram sensing system”
Nano-, Bio-, Info-Tech Sensors and 3D Systems III. Vol. 10969, 2019.
book chapters
3.J. Zuazola, A. Maharjan, R. Herbert.
“Integration of electronics with biological systems”
High, 2026.
2.R. Herbert, M. Popoola, W. Zhang, H. Cheng.
“Health monitoring from the skin”
Smart and Connected Wearable Electronics, 2022.
1.R. Herbert, WH. Yeo.
“Soft material-enabled packaging for stretchable and flexible hybrid electronics”
Nano-Bio-Electronic, Photonic and MEMS Packaging, 2021.
patents
3. WH. Yeo, R. Herbert, Y. Chun, M. Elsisy. “Nano sensor-embedded stent system and method”. U.S. Patent Application No. 18/278,712. (2024)
2. WH. Yeo, R. Herbert. “Wireless hemodynamic sensors and methods of using same”. U.S. Patent Application No. 17/664,167. (2021)
1. WH. Yeo, R. Herbert. “Implantable cerebral sensing devices and systems and methods related thereto”. U.S. Patent Application No. 17/600,775. (2021)